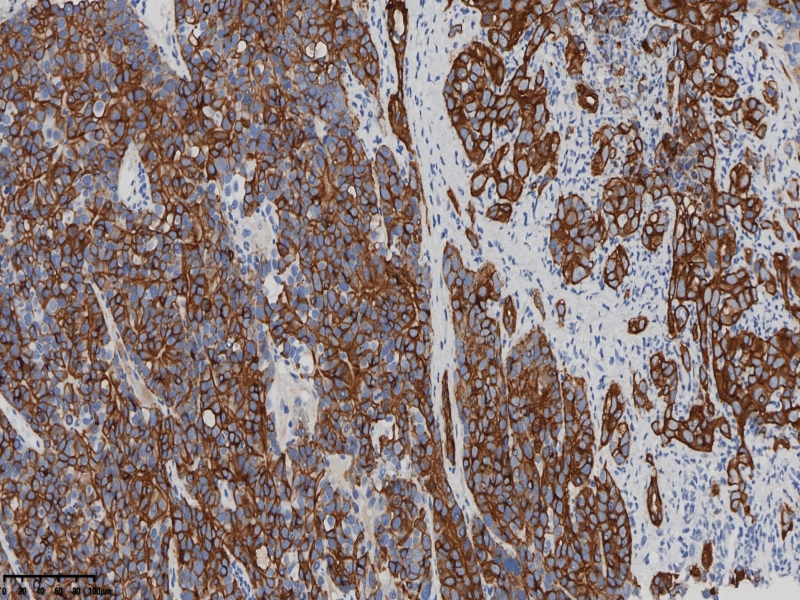
肝细胞肝癌？
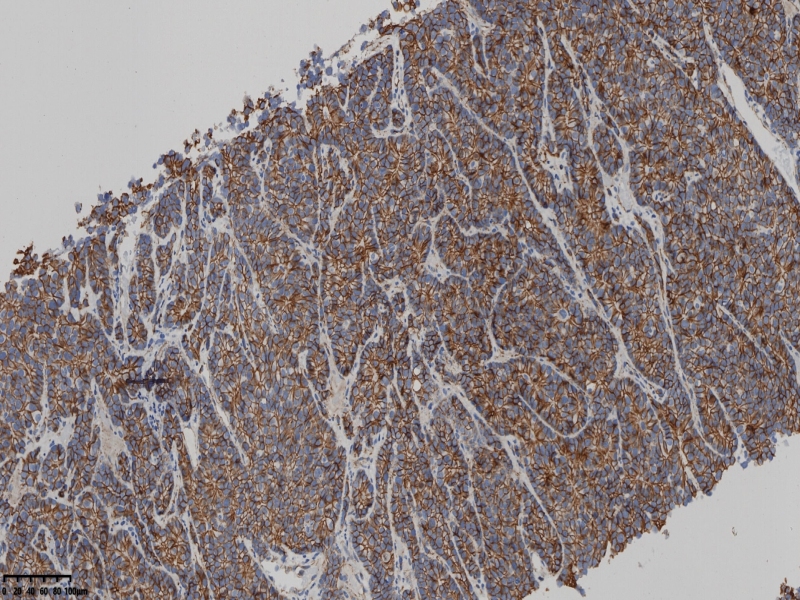
肝细胞肝癌？

我的博文
肝细胞肝癌?
2025-12-29 09:49
阅读(74)
评论(0)
分类:肝
男、71岁。强化CT:肝占位性病变较前增大。肝内多发乏血供病变及肝右叶异常强化灶。考虑多发转移可能,部分并不除外原发可能?门静脉、肝静脉及分支癌栓形成。门静脉海绵性变性。腹腔积液较前增多。双肺转移瘤较前加重。右心房及下腔静脉癌栓转移。双肺门区及纵膈内多发淋巴结转移及右侧心膈角区转移不除外。
送检肝穿刺组织。
镜下所见乳头状,条索样,实性小巣状瘤组织,异型明显,伴纤维组织增生,坏死。









免疫组化CK19+ Cateinn+a-AT+、Villin+
AFP、CEA、CA19-9、CK20、CK7、CDX-2、Heppar均阴性。
ki67
a-AT

CK19+
β-Catenin
Villin

会诊结果:肝细胞肝癌。
本文允许在互联网范围内转载,使用时请注明作者姓名、作品名称及作品来源。
上一篇:右卵巢肿物
下一篇:子宫多发性平滑肌瘤伴肉瘤?
我要评论
共0条评论